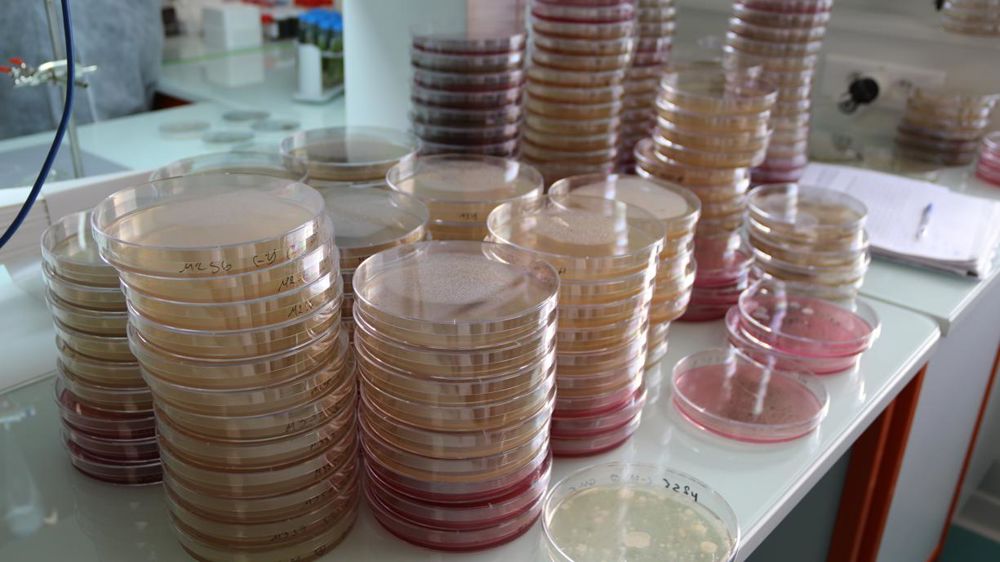
© Justine Papin

« 2010 était la décennie de la reconnaissance du biocontrôle. 2020 sera celle de son déploiement », résume Antoine Meyer, président d’IBMA France. Le marché du biocontrôle a en effet explosé en France : en 2018, il représentait 8 % du marché de la protection des plantes, et affiche une croissance à deux chiffres pour la troisième année consécutive. « Nous projetons de passer le cap des 30 % d’ici à 2030 », affirme-t-il.
Des ambitions fortes
Selon la définition inscrite depuis 2014 dans le code rural, les produits de biocontrôle sont « des agents et produits utilisant des mécanismes naturels dans le cadre de la lutte intégrée contre les ennemis des cultures ». Ils comprennent en particulier les macro-organismes et les produits phytopharmaceutiques comprenant des micro-organismes, des médiateurs chimiques comme les phéromones et les kairomones et des substances naturelles d’origine végétale, animale ou minérale.
« Le prochain objectif est de faire reconnaître le biocontrôle au niveau européen », indique IBMA. Didier Guillaume s’était d’ailleurs engagé dans ce sens en décembre 2018 : « La France est le seul État membre à s’être doté d’une réglementation biocontrôle. L’Europe est prête. Quand les européennes seront passées, j’irai avec vous à Bruxelles pour que cette reconnaissance européenne aille plus loin. »
Développer la recherche
Autre ambition de l’association : disposer de deux solutions de biocontrôle à modes d’action complémentaires, pour la majorité des usages, afin d’en assurer la pérennité, d’ici à 2030. Pour Antoine Meyer, la clé repose sur l’innovation et la recherche, sur le territoire français. « Avec une incitation forte, comme un crédit d’impôt à la recherche pour le biocontrôle majoré à 60 % pendant 10 ans, ce sont 100 à 200 postes affectés à la recherche sur le biocontrôle qui pourraient être créés en France, selon notre enquête interne, rapporte-t-il. Il faut remettre de la ressource humaine sur notre territoire. Qu’est-ce qu’on attend pour créer ces centres de recherche ? »
Une stratégie nationale de déploiement du biocontrôle est par ailleurs attendue en janvier 2020. Si les produits de biocontrôle sont exempts de l’interdiction des 3 R (les remises, rabais et ristournes) lors de la vente de produits phytosanitaires, ils sont en revanche bien concernés par la séparation de la vente et du conseil, ce qui pourrait nuire à leur promotion auprès des agriculteurs.
> À lire aussi :Phytos, 6 mois de sursis pour séparer le conseil et la vente ? (19/12/2019)